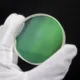

CSO-lentille d'objectif à double séparation 60mm à usage spécial pour la réfraction, bricolage pour télescope astronomique
8.05
–
22.99
$
2
commandes
/
4
avis
Évolution du prix
- pour 3 mois
- pour un semestre
- Nécessite l'extension Alitools
L'extension Alitools est nécessaire pour suivre un article et recevoir des notifications lorsque les prix baissent.
Avis de baisse de prix
7.65 $ (-5%)
7.65 $ (-5%)
7.25 $ (-10%)
6.84 $ (-15%)
6.44 $ (-20%)
Notre bot Telegram vous informera dès que le prix aura baissé jusqu'au prix souhaité
Cet article provient d'autres vendeurs
Produits similaires
Avis clients
F***r
7 août 2020
Super lenses!
F***r
5 juin 2020
perfect lenses!
Anonyme